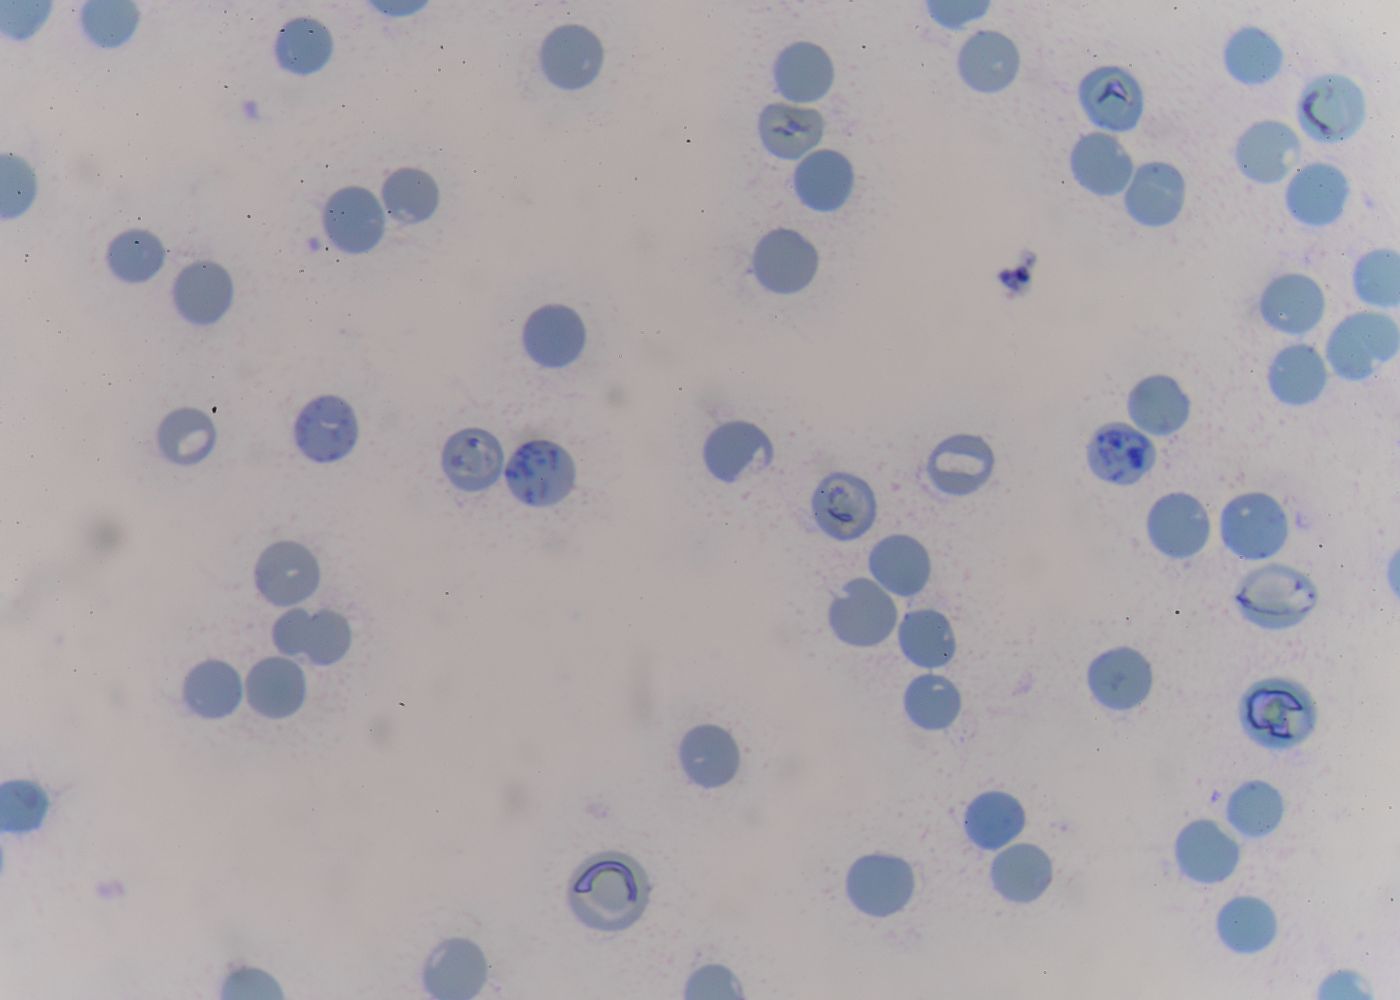

RETICULOCITOS
Prueba de laboratorio que mide la cantidad de glóbulos rojos inmaduros (reticulocitos) en la sangre para evaluar la función ósea.
Detalles de análisis
Indicaciones
No requiere ayuno.
Procedimiento
Se le tomará una muestra sanguínea.
Tiempo de entrega
Mismo día por la tarde.
Genetic Testing
¿Tienes alguna duda?
Consulta las dudas más frecuentes o comunicate con nosotros para una mejor atención
Trabajamos con la mejor tecnología y equipo para brindarte resultados certeros.
Te recomendamos acudir con tu médico para que interprete tus resultados en el contexto de tu salud. También puedes contactarnos si tienes dudas generales; nuestro equipo estará encantado de ayudarte a entender el proceso.
No siempre es necesaria una orden médica. Puedes acudir directamente para realizarte estudios básicos o de rutina. Sin embargo, algunos análisis especializados sí requieren indicación médica.